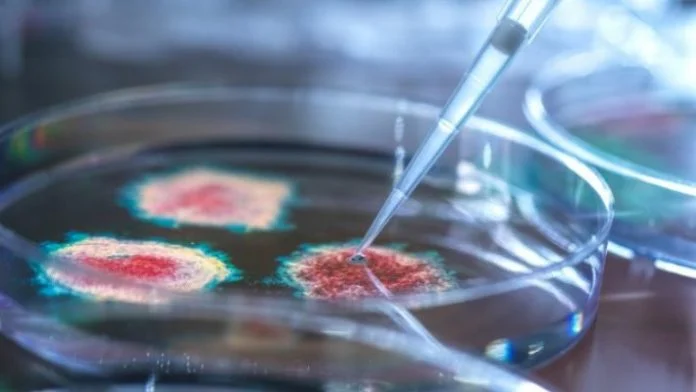
Lambda Koronavirus

Stručnjaci u Velikoj Britaniji izrazili su zabrinutost zbog BA.6, nove varijante COVID-19, koja je nedavno otkrivena u Danskoj.
Trisha Greenhalgh sa Univerziteta Oksford i Christina Pagel sa University College London objavile su na društvenim mrežama da nova varijanta korona virusa ima više mutacija.
“To bi potencijalno moglo uzrokovati veći val virusa”, kazala je Pagel, prenosi Anadolija.
Greenhalgh je rekla da mnogi stručnjaci već vode rasprave o BA.6, novoj varijanti COVID-19.
Ponovo ćemo nositi maske?
“Naučnici razgovaraju o tome. Na osnovu onoga što sam shvatila iz nekih detalja, čini se da je vrijeme da se ponovo nose maske”, kazala je.
Stephen Griffin sa Univerziteta u Leedsu izjavio je da BA.6 pokazuje najveću promjenu u COVID-19.
“Zabrinite se ako se počne širiti”, rekao je ovaj stručnjak, dodajući da ipak još uvije nedovoljno podataka otežava procjene o ovoj varijanti virusa.
Paul Hunter sa Univerziteta East Anglia ipak smatra da nova varijanta neće izazvati značajnu epidemiju te je preporučio nošenje maske samo ljudima sa zdravstvenim problemima.
Stručnjaci u Velikoj Britaniji izrazili su zabrinutost zbog BA.6, nove varijante COVID-19, koja je nedavno otkrivena u Danskoj.
Trisha Greenhalgh sa Univerziteta Oksford i Christina Pagel sa University College London objavile su na društvenim mrežama da nova varijanta korona virusa ima više mutacija.
“To bi potencijalno moglo uzrokovati veći val virusa”, kazala je Pagel, prenosi Anadolija.
Greenhalgh je rekla da mnogi stručnjaci već vode rasprave o BA.6, novoj varijanti COVID-19.
Ponovo ćemo nositi maske?
“Naučnici razgovaraju o tome. Na osnovu onoga što sam shvatila iz nekih detalja, čini se da je vrijeme da se ponovo nose maske”, kazala je.
Stephen Griffin sa Univerziteta u Leedsu izjavio je da BA.6 pokazuje najveću promjenu u COVID-19.
“Zabrinite se ako se počne širiti”, rekao je ovaj stručnjak, dodajući da ipak još uvije nedovoljno podataka otežava procjene o ovoj varijanti virusa.
Paul Hunter sa Univerziteta East Anglia ipak smatra da nova varijanta neće izazvati značajnu epidemiju te je preporučio nošenje maske samo ljudima sa zdravstvenim problemima.